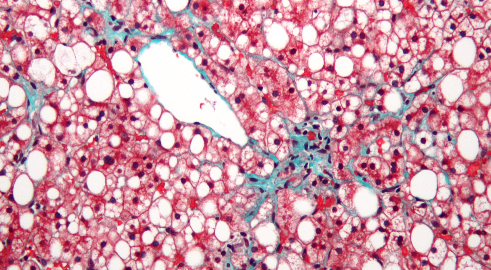

글루타치온은 건강과 미용을 동시에 챙기려는 현대인들에게 가장 인기 있는 영양소 중 하나입니다. 하지만 "먹어서는 효과가 없다"는 논란과 "피부 미백에 필수다"라는 찬사가 공존하며 소비자들을 혼란스럽게 만들기도 합니다.
오늘 이 글에서는 글루타치온의 정체부터 흡수율 논란의 진실, 그리고 그 효능을 극대화할 수 있는 과학적인 섭취 전략까지 상세히 파헤쳐 보겠습니다.


강력한 항산화의 마스터, 글루타치온의 실체
글루타치온은 글루탐산, 시스테인, 글리신이라는 세 가지 아미노산이 결합된 물질입니다.



우리 몸속의 모든 세포에서 스스로 생성되는 강력한 항산화제로, 체내 방어 시스템의 핵심 역할을 수행합니다. 하지만 나이가 들수록 체내 합성 능력이 떨어지기 때문에, 건강한 노년을 위해서는 현명한 보충 전략이 필요합니다.
글루타치온의 5가지 핵심 효능과 미백의 원리
글루타치온은 단순히 건강을 지키는 수준을 넘어 피부 미용에도 지대한 영향을 미칩니다.




1. 간 해독 및 체내 독소 제거
간은 우리 몸의 해독 공장입니다. 글루타치온은 간에서 독성 물질을 중화하고 배출하는 데 핵심적인 역할을 하며, 강력한 항산화 작용을 통해 간세포 손상을 방지하고 면역력을 향상시킵니다.


2. 피부 미백 및 멜라닌 억제


최근 가장 큰 주목을 받는 효능입니다. 피부색을 결정하는 것은 '멜라닌 색소'인데, 글루타치온은 멜라닌이 만들어지는 과정을 직접적으로 억제합니다. 이를 통해 기미와 잡티를 완화하고 전반적인 피부 톤을 맑게 만드는 미백 효과를 기대할 수 있습니다.
3. 피부 노화 방지 및 활성산소 제거





피부에 쌓이는 활성산소는 주름과 탄력 저하의 주범입니다. 글루타치온은 이 유해 산소를 억제하여 피부 노화를 늦추고 건강한 피부 장벽을 유지하도록 돕습니다.
4. 면역 체계 강화


바이러스나 세균에 저항하는 면역 세포의 기능을 활성화하여 신체 전반의 방어력을 높여줍니다.
5. 인슐린 저항성 개선 및 활력 증진



에너지 대사에 관여하여 체지방 연소를 돕고 인슐린 감수성을 높임으로써 만성 피로 개선과 성인병 예방에 기여합니다.
흡수율 논란의 진실: "먹는 영양제, 정말 효과 있나?"


많은 전문가들이 "글루타치온은 단백질이라 소화 과정에서 아미노산으로 분해되어 버리기 때문에 직접적인 흡수가 안 된다"고 주장합니다. 하지만 최근 연구와 논문들은 다른 결과를 보여줍니다.


분해되어도 다시 합성된다! 글루타치온 영양제를 먹으면 실제 체내 수치가 올라간다는 연구 결과가 많습니다. 이는 글루타치온이 아미노산으로 분해되어 흡수되더라도, 우리 몸속에 글루타치온을 만들기 위한 핵심 원료(아미노산)들이 충분히 공급되는 셈이라 체내에서 다시 글루타치온으로 합성되기가 훨씬 쉬워지기 때문입니다. 즉, 직접 흡수든 재합성이든 체내 수치를 올리는 데 분명히 기여한다는 것입니다.
흡수율을 극대화하는 최신 공법: 필름형과 리포좀
분해 과정을 최소화하고 효율을 높이기 위해 최근에는 두 가지 혁신적인 제형이 각광받고 있습니다.
- 구강용해 필름 (점막 흡수형): 입안 점막을 통해 혈관으로 직접 흡수시키는 방식입니다. 위장을 거치지 않기 때문에 소화효소에 의해 단백질이 분해되는 과정을 피할 수 있다는 강력한 장점이 있습니다.
- 리포좀(Liposomal) 글루타치온: 글루타치온 성분을 미세한 지방 막으로 둘러싼 형태입니다. 이 지방 막이 소화 효소로부터 성분을 보호하여 장벽을 통과해 세포까지 직접 전달될 수 있도록 돕습니다.
효능을 200% 끌어올리는 시너지 영양소 전략
글루타치온 혼자 일하게 두지 마세요. 다음 영양소들과 함께할 때 시너지는 극대화됩니다.

1. 재생의 파트너, 셀레늄 (브라질너트)
셀레늄은 사용된 글루타치온이 다시 자기 역할을 할 수 있도록 '재생'시켜주는 필수 미네랄입니다. 셀레늄이 부족하면 글루타치온은 반쪽짜리 효과밖에 내지 못합니다.
- 꿀팁: 영양제를 추가하기 부담스럽다면 브라질너트를 하루 2~3알만 드셔보세요. 천연 셀레늄이 매우 풍부하여 글루타치온의 효능을 즉각적으로 도와줍니다. (단, 5알 이상 과다 섭취는 주의하세요.)


2. 피부 미백의 단짝, 비타민 C
피부 노화 방지와 미백을 목적으로 한다면 비타민 C와 병용하는 것이 가장 좋습니다. 두 성분이 서로의 산화를 막아주며 피부 톤 개선 속도를 높여줍니다.
3. 항산화 도우미, 비타민 B2 (리보플라빈)
비타민 B2는 글루타치온이 항산화 작용을 하는 과정에서 필수적인 보조 역할을 수행합니다. 비타민 B군이 포함된 영양제를 함께 챙기시면 훨씬 효율적입니다.


요약 및 결론
글루타치온은 간 해독부터 피부 미백까지 우리 몸에 없어서는 안 될 마스터 항산화제입니다. 소화 과정에서의 분해 논란이 있지만, 원료 공급 차원에서도 영양제 섭취는 충분한 가치가 있으며, 특히 점막 흡수형이나 리포좀 제형을 선택하면 흡수율 고민을 덜 수 있습니다. 여기에 브라질너트(셀레늄)와 비타민 C를 곁들인다면 여러분의 항산화 관리와 피부 고민 해결은 더욱 완벽해질 것입니다.
'생활정보§' 카테고리의 다른 글
| 췌장암 정확한 등 통증 위치 (0) | 2026.02.02 |
|---|---|
| 췌장암 초기증상 (0) | 2026.02.02 |
| 강릉지역 영구임대아파트 입주 자격 (1) | 2026.01.29 |
| 공무원 파면과 해임의 차이점 (1) | 2026.01.29 |
| 군인 파면과 해임의 차이점, 항고 절차 가이드 (0) | 2026.01.29 |
댓글